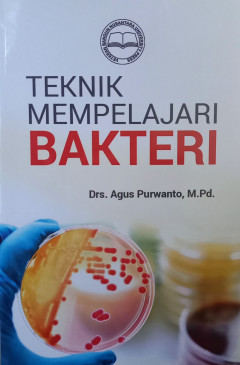
cover
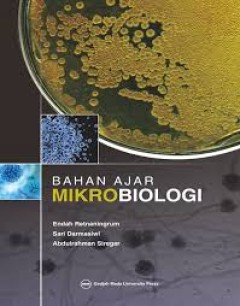
cover

Ditapis dengan

BAHAN AJAR MIKROBIOLOGI
- Edisi
- -
- ISBN/ISSN
- 978-602-386-175-0
- Deskripsi Fisik
- -
- Judul Seri
- -
- No. Panggil
- 579 RET b
- Edisi
- -
- ISBN/ISSN
- 978-602-386-175-0
- Deskripsi Fisik
- -
- Judul Seri
- -
- No. Panggil
- 579 RET b

BAHAN AJAR MIKROBIOLOGI
Buku ini disusun untuk membantu para mahasiswa S-1 di Fakultas Biologi UGM dalam memahami konsep dasar teoretis mengenai mikrobiologi dasar yang hingga saat ini buku ajar dan pustaka mengenai mikrobiologi dalam bahasa Indonesia masih sangat terbatas. Selain itu, buku ini diharapkan membantu mahasiswa memahami dan mempersiapkan diri dalam perkuliahan maupun melalui pustaka yang terkait (learning…
- Edisi
- -
- ISBN/ISSN
- -
- Deskripsi Fisik
- XVI; 15,5 cm x 23 cm; 152 hlm
- Judul Seri
- -
- No. Panggil
- 579 RET b

BAHAN AJAR MIKROBIOLOGI
Buku ini disusun untuk membantu para mahasiswa S-1 di Fakultas Biologi UGM dalam memahami konsep dasar teoretis mengenai mikrobiologi dasar yang hingga saat ini buku ajar dan pustaka mengenai mikrobiologi dalam bahasa Indonesia masih sangat terbatas. Selain itu, buku ini diharapkan membantu mahasiswa memahami dan mempersiapkan diri dalam perkuliahan maupun melalui pustaka yang terkait (learning…
- Edisi
- -
- ISBN/ISSN
- -
- Deskripsi Fisik
- XVI; 15,5 cm x 23 cm; 152 hlm
- Judul Seri
- -
- No. Panggil
- 579 RET b

BAHAN AJAR MIKROBIOLOGI
Buku ini disusun untuk membantu para mahasiswa S-1 di Fakultas Biologi UGM dalam memahami konsep dasar teoretis mengenai mikrobiologi dasar yang hingga saat ini buku ajar dan pustaka mengenai mikrobiologi dalam bahasa Indonesia masih sangat terbatas. Selain itu, buku ini diharapkan membantu mahasiswa memahami dan mempersiapkan diri dalam perkuliahan maupun melalui pustaka yang terkait (learning…
- Edisi
- -
- ISBN/ISSN
- 978-602-386-175-0
- Deskripsi Fisik
- XVI; 15,5X23; 152 hlm
- Judul Seri
- -
- No. Panggil
- 579 RET b

UVBN - ANATOMI TUMBUHAN
Di dalam perkuliahan sangat terbatas sekali waktunya untuk memberikan materi yang sejelas-jelasnya tentang bahan perkuliahan khususnya Anatomi Tumbuhan. Oleh karena itu buku pegangan perkuliahan bagi mahasiswa, khususnya perkuliahan Anatomi Tumbuhan yang banyak memuat materi yang disertai gambar-gambar anatomi tumbuhan sangat dibutuhkan.
- Edisi
- -
- ISBN/ISSN
- 9786234203295
- Deskripsi Fisik
- 15,5X23; VII; 125
- Judul Seri
- -
- No. Panggil
- 571.3 HAN a

UVBN - LOGIKA DAN HIMPUNAN
- Edisi
- -
- ISBN/ISSN
- 978-623-119-091-8
- Deskripsi Fisik
- VIII,15X23CM,146
- Judul Seri
- -
- No. Panggil
- 511.3 HAD l
- Edisi
- -
- ISBN/ISSN
- 978-623-119-091-8
- Deskripsi Fisik
- VIII,15X23CM,146
- Judul Seri
- -
- No. Panggil
- 511.3 HAD l

UVBN - TEKNIK MEMPELAJARI BAKTERI
- Edisi
- -
- ISBN/ISSN
- 9786021107287
- Deskripsi Fisik
- xvi; 98; 15X23
- Judul Seri
- -
- No. Panggil
- 579.3 PUR t
- Edisi
- -
- ISBN/ISSN
- 9786021107287
- Deskripsi Fisik
- xvi; 98; 15X23
- Judul Seri
- -
- No. Panggil
- 579.3 PUR t

UVBN - TRIGONOMETRI
- Edisi
- -
- ISBN/ISSN
- 9786230201738
- Deskripsi Fisik
- 23 ;L15.5 ;HLM122
- Judul Seri
- -
- No. Panggil
- 516.24 SUS t
- Edisi
- -
- ISBN/ISSN
- 9786230201738
- Deskripsi Fisik
- 23 ;L15.5 ;HLM122
- Judul Seri
- -
- No. Panggil
- 516.24 SUS t

UVBN - GEOMETRI
- Edisi
- -
- ISBN/ISSN
- 978-623-119-096-3
- Deskripsi Fisik
- VIII; 15,5 cm x 23 cm; 121 hlm
- Judul Seri
- -
- No. Panggil
- 516 HAD g
- Edisi
- -
- ISBN/ISSN
- 978-623-119-096-3
- Deskripsi Fisik
- VIII; 15,5 cm x 23 cm; 121 hlm
- Judul Seri
- -
- No. Panggil
- 516 HAD g
UVBN - KOMBINATORIK STATISTIKA BERBASIS PBL
Matematika merupakan bidang studi penting yang diajarkan di tingkat sekolah karena mendasari tumbuhnya logika berpikir. Materi pada buku ini disusun secara singkat, padat, dan mudah dipahami, dengan susunan materi sebagai berikut : Bab 1 : KAIDAH PENCACAHAN, PERMUTASI, DAN KOMBINASI. Bab 2 : PELUANG KEJADIAN. Bab 3 : STATISTIKA. Bab 4 : PEMBELAJARAN PBL.
- Edisi
- -
- ISBN/ISSN
- 978-623-8540-53-2
- Deskripsi Fisik
- viii; 15,5 cm x 23 cm; 180 hlm
- Judul Seri
- -
- No. Panggil
- 519.5 HID k
 Karya Umum
Karya Umum  Filsafat
Filsafat  Agama
Agama  Ilmu-ilmu Sosial
Ilmu-ilmu Sosial  Bahasa
Bahasa  Ilmu-ilmu Murni
Ilmu-ilmu Murni  Ilmu-ilmu Terapan
Ilmu-ilmu Terapan  Kesenian, Hiburan, dan Olahraga
Kesenian, Hiburan, dan Olahraga  Kesusastraan
Kesusastraan  Geografi dan Sejarah
Geografi dan Sejarah